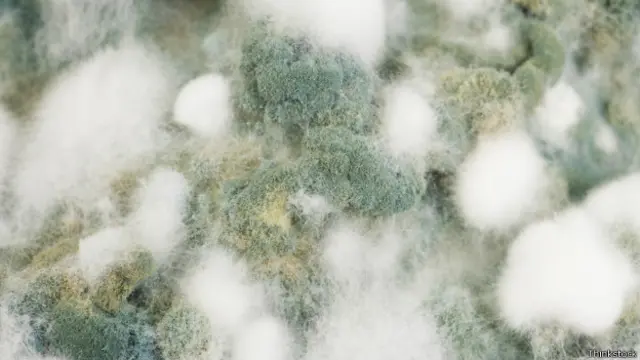
грибы

Чудеса, на которые способны грибы

Автор фото, Thinkstock
- Автор, Кэт Адамс
- Место работы, BBC Earth
Пусть их небольшие размеры вас не обманывают: грибы способны на настоящие чудеса. Корреспондент <link type="page"><caption> BBC Earth</caption><url href="http://www.bbc.com/earth" platform="highweb"/></link> собрал шесть удивительных фактов о жизни грибов.
Грибы дали человеку алкоголь
Невозможно написать оду грибам, начав не с алкоголя.
Одна из групп грибов - дрожжи - вырабатывает энергию в процессе ферментации, побочными продуктами которой являются углекислый газ и спирт.
Для большинства микроорганизмов спирт - это яд, но дрожжи сумели выработать толерантность к высоким градусам в процессе эволюции.
Ценить богатые питательными веществами и не содержащие губительных бактерий напитки человечество научилось примерно 10 тысяч лет назад, задолго до изобретения пастеризации и холодильников. Некоторые ученые, в частности биомолекулярный археолог Патрик Макгаверн, даже считают, что наши предки начали выращивать и хранить зерновые культуры не потому, что им было нужно больше хлеба, а ради спирта.
Макгаверн - научный директор Биомолекулярно-археологического проекта по кулинарии, ферментированным напиткам и здравоохранению в музее Пенсильванского университета в США. Он обнаружил, что навязчивый интерес к алкоголю появился у человека куда раньше, чем принято считать. Ученый секвенировал ДНК дрожжей из древнеегипетских сосудов для вина, возраст которых превышает 5 тысяч лет (эти дрожжи оказались предками современных ферментационных дрожжей Saccharomyces cerevisiae). В Китае Макгаверн нашел свидетельства того, что люди производили спиртное еще раньше - более 9 тысяч лет назад, то есть задолго до изобретения колеса. Такие вот были приоритеты.
Грибной ветер
Помимо производства безумного количества дрожжей грибы умеют вызывать ветер.
В каком-то смысле гриб похож на фрукт, висящий на дереве. Шляпка гриба полна спор, как фрукт - семян. Однако в отличие от дерева, большая часть гриба скрыта под землей. Грибница формирует сеть, соединяющую грибы на поверхности.
Автор фото, Thinkstock
Грибам нужно, чтобы их споры разлетались на как можно большее расстояние; тогда потомство не будет конкурировать со своими "родителями" за питательные ресурсы. При этом рассчитывать на помощь животных в путешествиях на большие расстояния грибы не могут. Им приходится полагаться на себя и использовать имеющиеся ресурсы. Главный из них - вода.
Когда приходит время распылять споры, грибы выпускают водяной пар, таким образом охлаждая вокруг себя воздух. Потоки воздуха создают подъемную силу, которая может унести споры на расстояние до 10 сантиметров во все стороны.
Грибы порождают зомби
Ветер - это еще что. Некоторым грибам под силу породить настоящий ходячий кошмар.
Грибы вида Ophiocodyceps, живущие в тропических лесах, селятся в мозгу муравьев-древоточцев. Тайский гриб Ophiocordyceps unilateralis заставляет муравья совершать хаотичные движения, из-за чего насекомое падает с листвы на землю. После этого гриб велит муравью взобраться на ствол дерева на высоту чуть меньше метра - то есть туда, где созданы идеальные по температуре и влажности условия для роста гриба.
Он контролирует не только высоту, на которую поднимается муравей, но и направление - обычно это северо-северо-запад. Обычно муравьи не жуют листья с дерева, однако насекомые, пораженные грибами, начинают их грызть. Причем поедать листья зомби-муравьи начинают ровно в полдень - факт, достойный научной фантастики.
В этом необычном положении муравей умирает. В посмертном окоченении челюсти насекомого продолжают стискивать лист, поскольку мышцы муравья атрофируются из-за прорастающего сквозь голову гриба. Тело остается в такой позе до двух недель. Гриб, тем временем, готовится к размножению. Наконец, он осыпает своими спорами здоровых муравьев, которые, ни о чем не подозревая, продолжают добывать пищу, чтобы отнести ее в свои гнезда в древесной кроне.
Цикл зомбификации повторяется.
Этот вид грибов отточил свое мастерство зомбификации до высочайшего уровня. Оно вдохновило создателей фильмов и видеоигр, а также инициировало краудфандинговую кампанию по поиску генов, отвечающих за управление муравьем.
Кто же не любит истории про зомби?
Грибы быстрее пуль
Когда речь заходит о скорости выставления потомства из дома, грибам нет равных среди живых организмов.
Споры навозного гриба Pilobolus crystallinus летят быстрее пуль и любых живых организмов на нашей планете.
С виду Pilobolus не похож на обычный гриб. Он напоминает крошечную прозрачную змейку со шляпой-котелком на голове. Эта шляпка - мешок со спорами, и гриб умеет ее отстреливать, причем максимальная скорость движения мешка со спорами может достигать 25 метров в секунду, а ускорение - 1,7 миллиона метров в секунду в квадрате. Для сравнения, американская ракета "Сатурн-5", которая использовалась при запуске второй лунной миссии "Аполлон-8", разгонялась не быстрее 40 метров в секунду в квадрате.

Автор фото, Jason Hollinger CC by 2.0
Неудивительно, что в англоязычном мире этот гриб называют "шляпометом".
Если захотите сравнить эту навозную пушку с огнестрельным оружием, предлагаем вашему вниманию замечательный <link type="page"><caption> сюжет</caption><url href="https://www.youtube.com/watch?v=T8OAmcUnm4g" platform="highweb"/></link> программы Earth Unplugged.
Спойлер: да, споры Pilobolus летят быстрее пули и дроби.
28 тысяч вариантов пола
Сейчас мы утешим всех, кто когда-либо отчаянно пытался отыскать любовь всей своей жизни в море посредственных вариантов. Все было бы гораздо хуже, будь вы грибом щелелистником в поисках своей половинки.
Да, некоторые грибы сексуальной фантазией не отличаются. У дрожжей всего два пола, которые определяются с помощью половых генов - назовем их тип 1 и тип 2. Дрожжи первого типа могут скрещиваться с дрожжами второго, то есть с половиной всей дрожжевой цивилизации.
Недостаток такой схемы заключается в том, что индивид сексуально совместим со своими братьями или сестрами. Если других грибов поблизости нет, то они могут произвести потомство - но отпрыски от такого союза будут недостаточно генетически разнообразными.
Щелелистники обыкновенные подходят к делу иначе. У этих распространенных грибов каждый половой ген может иметь сотни вариаций. Чтобы быть сексуально совместимыми, два гриба должны иметь разные версии обоих генов. Другими словами, каждый ген партнера должен быть другого "пола". 28 тысяч полов кажутся излишними, но генетическое разнообразие помогает лучше реагировать на возникающие угрозы. Угрозы могут быть экологическими - засуха или пожар - и биологическими. К последним относятся паразиты.

Автор фото, Silver Leapers CC by 2.0.jpg
Грибные паразиты, на самом деле, могут быть деликатесами - взять гипоцимес млечниковый. Он растет на обычных грибах, окрашивая их в красноватый оттенок, похожий на цвет вареного лобстера. Выглядит такой франкенгриб довольно странно, но ценится высоко - в районе 50 долларов за килограмм.
Самый большой живой организм на Земле - это грибница
Наконец, ничто живое не может сравниться с грибами по размерам. В американском штате Орегон есть опёнок темный, который простирается на 10 квадратных километров. Его возраст - от 1900 до 8650 лет. Однако, несмотря на поистине гигантские размеры, обнаружить гриб смогли лишь в XXI веке.
Опёнок темный растет в основном под землей. Этот вид - древесный паразит, он заражает живые деревья белой гнилью и существует в основном в виде трубчатых нитей - гифов. Гифы разрастаются в подземную сеть, соединяющую корни деревьев.
Сами грибы мы видим только тогда, когда наступает время размножения. Если бы грибы не вели половую жизнь, мы могли бы и не подозревать об их существовании.
Ученые смогли выяснить, что грибница опят способна достигнуть настолько гигантских размеров, лишь с появлением технологии секвенирования ДНК. После анализа образцов ДНК грибов в этом районе ученые поняли, что все опята генетически идентичны.
С помощью этого же метода исследователи начали изучать колонии микроскопических грибов, обитающих в почве и воде, в растениях и животных и даже в самом воздухе. Скорость, с которой специалисты обнаруживают все новые виды грибов, заставила их оценить общее количество этих видов на Земле в более чем пять миллионов.
На какие еще невероятные подвиги способны пока что не известные нам грибы?
<italic>Прочитать <link type="page"><caption> оригинал этой статьи</caption><url href="http://www.bbc.com/earth/story/20150202-six-bizarre-things-about-fungi" platform="highweb"/></link> на английском языке можно на сайте <link type="page"><caption> BBC Earth</caption><url href="http://www.bbc.com/earth" platform="highweb"/></link>.</italic>



















